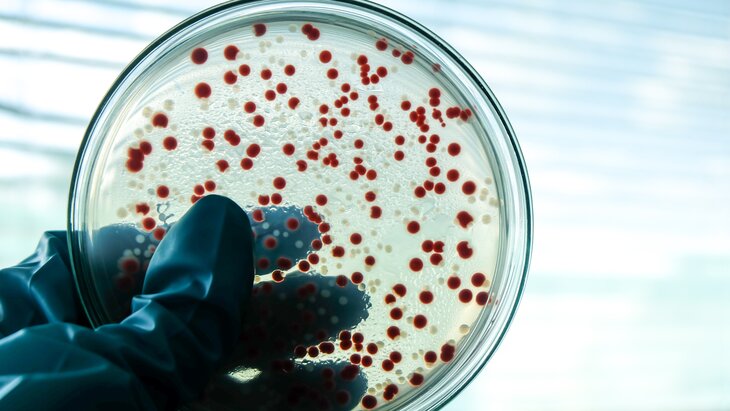

Ученые из США: кишечные бактерии вырабатывают вредное для сердца вещество

Фото: 123RF/orawanpat
Ученые Государственного университета в Кливленде (США) выяснили, что кишечные бактерии вырабатывают вещества, которые напрямую воздействуют на клетки сердца.
Микробиом кишечника и здоровье
Согласно исследованию, в последние годы значительный интерес вызывает вопрос взаимодействия микробиома кишечника на здоровье человека. Особенно любопытны те случаи, когда метаболиты, синтезируемые бактериями в кишечнике, непосредственно влияют на восприимчивость к заболеваниям.
Кроме того, недавно ученые обнаружили фенилацетилглутамин (PAGln), которые синтезируется кишечником и связан с риском развития сердечно-сосудистых заболеваний. Поэтому американские ученые решили подробно изучить влияние нового вещества на сердце.
Что удалось выяснить
Фото: 123RF/tinydevil
В ходе исследования выяснилось, что PAGln попадает в кровоток и достигает сердца. Дело в том, что он взаимодействует с бета-2 адренорецепторами. Это белки, которые играют важную роль в реакции организма на стресс.
Сегодня в медицине используют бета-блокаторы, которые лечат сердечную недостаточность и гипертонию. Эти препараты блокируют бета-2 адренорецепторы, замедляя сердцебиение и снижая нагрузку на сердце. Однако полученная информация о PAGln побуждает к созданию более точных и безопасных лекарств.
Разработка безопасных лекарств
Американские ученые планируют создать новые препараты, которые будут избирательно блокировать негативное воздействие PAGln на сердце. При этом лекарство не должно мешать работе других сигналов, которые передаются через бета-2 адренорецепторы.
Специалисты уверены, что новый препарат сможет изменить подход к лечению сердечно-сосудистых заболеваний и снизить риск побочных эффектов. Об этом говорится в исследовании, опубликованном в Nature.
Ранее врач-гастроэнтеролог рассказала, что при синдроме "дырявого кишечника" человек страдает от проблем с кожей, вздутия живота, непереносимости продуктов и других симптомов.
Старкина Маргарита



















